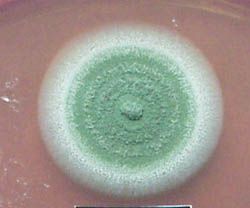

เชื้อราเขียว เมตาไรเซียม (Metarhizium anisopliae)

Metarhizium anisopliae, อดีต Entomophthora anisopliae ( basionym ),เห็ดที่เติบโตในธรรมชาติคือดิน และทำให้เกิดโรคต่าง ๆ ทั่วโลกโดยมีอำนาจหน้าที่ในฐานะปรสิต แมลงมันมีมานานแล้วจำได้ว่าเป็นเอกเทศเฉพาะ และพวกเขาได้รับมอบหมายวาไรตี้สถานะ[1]แต่ตอนนี้พวกเขาได้รับมอบหมายใหม่ Metarhiziumสายพันธุ์[2]เช่นเอ็มanisopliae, เอ็มmajusและเอ็มacridum (ซึ่งคุณanisopliaeวาร์ได้ acridumและรวมถึงใช้แยกตั๊กแตนควบคุม) ได้ถูกนำมาวางในเอ็มanisopliae anisopliaeมาวาร์ Metarhizium taii[3]แต่บัดนี้ถูกอธิบายว่าเป็นไวพจน์ของเอ็มguizhouense (ดู Metarhizium )




โรคที่เกิดจากเชื้อรา ซึ่งบางครั้งเรียกว่าโรค เพราะสีของมันสดเขียวmuscardine สปอร์เมื่อสปอร์ (อวัยวะเพศ) ทิคส์ (เรียกว่า conidia ) เชื้อราที่เข้ามาติดต่อกับเรือนร่างของแมลงจำนวนมาก มันแตกหน่อและ hyphaeปรากฏว่าทะลุหนังกำพร้าจากนั้นก็พัฒนาขึ้นในร่างกายฆ่าเชื้อราแมลงในที่สุดหลังจากผ่านไปสองสามวัน; นี้ผลก็คือได้รับความช่วยเหลือจากการผลิตมากถึงinsecticidalวงจร peptides (destruxins) ด้านนอกของซากศพบ่อย ๆ กลายเป็นสีแดง ถ้าความชื้นสูงพอรอบ สีขาวจากนั้นก็ขึ้นบนซากศพนั้นไม่นานรากลายเป็นสีเขียวที่ผลิตสปอร์ ส่วนใหญ่แมลงที่อาศัยอยู่ใกล้พื้นดินมีวิวัฒนาการตามธรรมชาติเพื่อป้องกันเชื้อราเหมือนentomopathogenic anisopliae เอ็มนี่จึงเป็นสิ่งที่ถูกขังอยู่ในการต่อสู้เพื่อเอาชนะราเจริญการป้องกัน ซึ่งได้นำไปเป็นจำนวนมาก (หรือเพลง) ว่าปัจเจกชนจะเหมาะกับฝูงแมลง[4]
อิลยาซีกันMechnikovชื่อ Metarhizium anisopliaeหลังจากแมลงชนิดนี้คือโดดเดี่ยวจากเดิม: ที่ด้วง anisoplia austriaca มันคือ mitosporicเห็ดกับเพศพันธุ์ซึ่งเคยเป็นความลับในรูปแบบของแบบฟอร์ม Hyphomycetes ชั้น ประเภท Deuteromycota (มักเรียกว่ายังเห็ดImperfecti ) ที่ถูกนำมาใช้เพื่อนำเห็ดที่อยู่ด้วยกันตลอดDeuteromycotaไม่มีเพศเวที ( teleomorph ) เป็นที่รู้จัก ดังนั้นจึงเป็นเรื่องไม่จริงแท็กซอนในความหมายคลาสสิค เรื่องนี้เป็นที่รู้กันว่าติดเชื้อมา 200 entomopathogenicเห็ดแมลงศัตรูพืชพันธุ์ รวมทั้งปลวก[5]ขณะนี้ทางชีวภาพที่ใช้เพื่อควบคุมจำนวนแมลงแมลงเช่นปลวก เพลี้ยฯลฯ และนำมาใช้ในการควบคุม-ส่งมาลาเรียอยู่ภายใต้การสอบสวนยุง[6] anisopliae เอ็มของมนุษย์ หรือสัตว์อื่น ๆ ที่ไม่ปรากฏเชื้อ และปลอดภัยเหมือนแมลง วัดต่าง ๆ ในพื้นที่ได้รับการฉีดสปอร์ อาจเป็นเทคนิคที่ใช้เพื่อควบคุมคือเสื้อมาลาเรีย อวนมุ้งหรือผ้าฝ้ายที่ติดอยู่กับฝาผนังด้วย